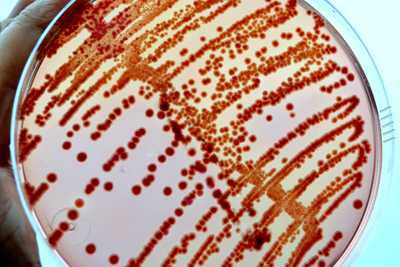
petri dish with red dots in smear pattern
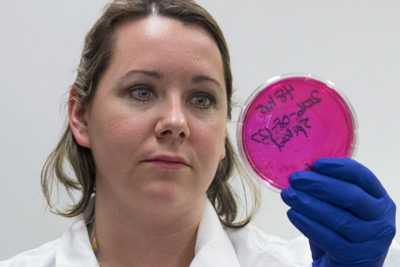
Image of scientist holding a red petri dish

Our Work: 2016
Our Work - 2016
Zika update
Even though colder temperatures have arrived in many areas, Zika virus transmission continues to be a concern in parts of the globe, including the United States.
On November 28, Texas health officials reported that Zika virus infection in a resident of Brownsville, Texas may have been spread by local mosquitoes. This may be the first case of local mosquito-borne Zika virus transmission in the state. CDC is closely coordinating with Texas and local officials to increase surveillance and vector control efforts in the Brownsville area.
CDC continues efforts with Florida health officials to fight Zika and investigate cases in Miami-Dade County, Florida. On November 22, CDC updated guidance for Miami Beach, Florida. The North and South Miami Beach sections are now being considered separately because no new cases of local Zika virus transmission were identified in North Miami Beach after three mosquito incubation periods passed (45 days), suggesting that the risk of Zika virus infection in North Miami Beach is no longer greater than in the rest of Miami-Dade County. North Miami Beach is now designated as a Zika cautionary area (yellow area) and South Miami Beach continues to be a Zika active transmission area (red area).
CDC also continues to support the Zika response in other areas of the globe. As of November 29, 98 CDC staff members were deployed for the Zika response, and 982 had completed deployments. A total of 45 CDC employees continued to support the response in Puerto Rico, where 31,944 locally acquired cases had been reported as of November 23. The MMWR “Incidence of Zika Virus Disease by Age and Sex – Puerto Rico, November 1, 2015-October 20, 2016” was published on November 11. This report showed that among more than 28,200 non-pregnant people with laboratory-confirmed Zika in Puerto Rico, Zika infection was highest among women ages 20 to 49.
Additionally, CDC has published an updated version of the Guidance for US Laboratories Testing for Zika Virus Infection, which provides updated recommendations for testing of specimens by US laboratories for possible Zika virus infection. CDC also has published Zika virus infection control guidance for healthcare workers. The guidance describes the standard precautions that should be used to protect healthcare personnel from all infectious disease transmission, including Zika virus, and other advice for healthcare workers.
On November 18, the WHO changed the classification of Zika and its related consequences from a Public Health Emergency of International Concern as defined under the International Health Regulations to an enduring public health challenge requiring intense action. Noting that many aspects of Zika still remain to be understood, the WHO Executive Committee recommended that what is needed now is a sustained program of work with dedicated resources to address the long-term nature of the disease and its associated consequences.
FoodNet Fast online tool

CDC just launched FoodNet Fast, an interactive tool that makes it easy to create custom searches from the Foodborne Diseases Active Surveillance Network (FoodNet), which covers about 15% of the United States population.
Users can see how rates of illnesses have changed over the past 20 years for the nine pathogens transmitted commonly by food that FoodNet tracks: Campylobacter, Cryptosporidium, Cyclospora, Listeria, Salmonella, Shiga toxin-producing Escherichia coli (STEC) O157 and non-O157, Shigella, Vibrio, and Yersinia.
People and organizations can use FoodNet Fast data to quickly and easily learn how many cases occurred in certain areas or over certain time periods, which groups were affected, and how the number of cases changed over time. For more information about FoodNet, visit https://www.cdc.gov/foodnet/index.html.
Candida auris now in US

CDC announced 13 cases of Candida auris, an emerging drug-resistant fungus, in the United States through a press release on November 4, 2016. C. auris is often resistant to multiple antifungal drugs and seems to spread in healthcare settings. Such high levels of resistance and healthcare transmission are not usual for other Candida species. An MMWR Early Release on November 11 detailed the first 7 cases from May 2013 through August 2016. The additional 6 cases are still under investigation. CDC’s C. auris webpage was updated to include a US map of cases and interim recommendations on laboratory diagnosis and infection control.
NCEZID website enhancements
Now you can find all the new NCEZID website content that’s refreshed each month on one page! Each month, on the What’s New page, you can find links to recent work, media releases, new videos, infographics, features, blog posts, and more. Aggregating all new content about NCEZID activities on a “one-stop-shop” page provides a quick snapshot of recent center highlights.
¿Habla español? Our new NCEZID en Español website provides access to Spanish speakers. The site includes evergreen content describing what we do, an organizational chart, and translations of the NCEZID strategic plan and 2015 accomplishments. Links to new NCEZID-related Spanish content will be periodically updated.
Risk of infection during open heart surgery

CDC recently warned healthcare providers and patients about the potential risk of infection from certain devices used during open heart surgery. This advice follows an investigation report including new whole genome sequencing results published in MMWR indicating that some LivaNova PLC (formerly Sorin Group Deutschland GmbH) Stöckert 3T heater-cooler devices, used during many of these surgeries, might have been contaminated during manufacturing, which could put patients at risk for life-threatening infections. CDC distributed a HAN and press release to inform clinicians and patients of the risk and a notification toolkit to assist healthcare facilities with notifying patients.
Zika update

As mosquitoes continue to spread Zika virus in parts of Miami-Dade County, Florida, CDC is continuing efforts with Florida health officials to fight the disease and investigate new cases of locally transmitted Zika virus infection.
On October 13, Florida announced a new area of mosquito-borne spread of Zika in a 1-square-mile area in Miami-Dade County, in addition to the existing 4.5-square-mile area in Miami Beach. CDC has strengthened travel recommendations for pregnant women to Miami-Dade County and is reinforcing recommendations for use of protective measures to prevent exposure to Zika. As described in a Health Alert Network update released October 19, CDC advises pregnant women to consider postponing travel to all areas of Miami-Dade County and to specifically avoid travel to the previously identified 4.5-squre-mile area of Miami Beach and 1-square-mile area in Little River located in Miami-Dade County. Women and men who are planning to conceive in the near future should consider avoiding nonessential travel to the identified areas.
Continuing this work is important, as Zika transmission continues in many territories and countries. As of October 26, 139 locally transmitted cases of Zika have been reported in the continental United States, all in Florida. Zika continues to spread in Puerto Rico, where 28,111 locally acquired cases of Zika had been reported as of October 26. CDC continues to intensify activities to help Puerto Rico prevent Zika virus infection, especially among pregnant women.
Supplemental funding announced
On October 21, CDC announced the availability of about $70 million in supplemental funding to states, cities, and territories to support continued efforts to protect Americans from Zika virus. The funding, distributed through the Epidemiology and Laboratory Capacity for Infectious Diseases (ELC) Cooperative Agreement, will support vital activities to protect the health of Americans, especially pregnant women, including epidemiologic surveillance and investigation, improving mosquito control and monitoring, and strengthening laboratory capacity. Funding also will support participation in the US Zika Pregnancy Registry to monitor pregnant women with Zika and their infants.
CDC awards $14 million to study microbiome
On October 6, CDC awarded more than $14 million through a broad agency announcement to fund 34 projects seeking new approaches to combat antibiotic resistance. The awards support activities related to the CDC Antibiotic Resistance Solutions Initiative and the National Action Plan for Combating Antibiotic-Resistant Bacteria.
The projects will include research on how the microbiome can be used to predict and prevent infections caused by drug-resistant organisms. The microbiome is a community of naturally occurring microbes in and on our bodies. It is often the body’s first line of defense against infections. Antibiotics can disrupt the microbiome by changing the balance of good and bad bacteria, putting people at risk for potentially untreatable illnesses. The research projects will study how antibiotics disrupt a healthy microbiome, how a disrupted microbiome puts people at risk, and how antibiotic stewardship protects the microbiome.
Responding to Rift Valley fever outbreak

CDC’s Viral Special Pathogens Branch (VSPB) is providing support for the response in Niger in West Africa to an outbreak of Rift Valley fever, a virus commonly found in animals such as cattle and sheep, but can also infect and cause illness in people. VSPB staff and others at CDC are sharing scientific and communications expertise with the US Embassy in Niger, WHO, and the Food and Agriculture Organization (FAO) of the United Nations.
As of October 19, 132 cases of Rift Valley fever in people, with 31 deaths, had been reported to WHO. There have also been reports of illness and spontaneous abortions among animals. There is concern the outbreak could spread to neighboring countries due to the seasonal movement of nomadic herdsmen and as herders and their animals return home from a recent regional festival that brought together herders and 2 million livestock.
Outbreak of shigellosis in Michigan

CDC staff were deployed to Michigan to investigate shigellosis outbreaks in Genesee and Saginaw counties. Shigellosis is a diarrheal disease caused by a group of bacteria called Shigella. Shigella infection causes about 500,000 cases of diarrhea in the United States annually. The two counties reported 177 cases of shigellosis since March. Most who are infected with Shigella develop diarrhea, fever, and stomach cramps starting a day or 2 after they are exposed to the bacteria. The team is assisting state and local health officials to determine the magnitude of the outbreak, identify the chains of transmission and risk factors, map existing data related to water quality from municipal systems, and communicate to the community about the outbreak and investigation.
The UN General Assembly addresses antibiotic resistance

At the United Nations General Assembly in September, all 193 member states agreed to a declaration to combat antimicrobial resistance. This was only the fourth time global leaders had convened to specifically discuss a health topic.
CDC Director Dr. Tom Frieden met with world leaders to reinforce the importance of continued global action to fight antimicrobial resistance, the need to slow its potentially devastating impact on people, plus its threat to sustainable development goals, modern medicine, and food security. The declaration includes a focus on developing surveillance for and regulation of antibiotic use in humans and animals, finding innovative ways to develop new antibiotics, and increasing awareness among healthcare professionals and the public on preventing resistant infections.
Zika update

Fall is here, but the Zika response is not slowing. As of September 27, there have been a total of 757 completed deployments for the Zika response, and 109 are currently deployed both domestically and internationally. This work is crucial, as Zika transmission continues in many territories and countries, including a small section of Miami-Dade County in Florida.
Mosquito-borne spread of Zika continues in a section of Miami-Dade County, Florida. On September 17, the section of Miami Beach where active Zika transmission has been identified was expanded to a 4.5-square–mile area. No new cases of local transmission have been reported in the Wynwood area since early August, and low numbers of mosquitoes have been found in traps there for the past several weeks. By September 19, three mosquito incubation periods had passed without any new locally transmitted cases of Zika in the Wynwood area. On September 23, CDC published an MMWR detailing the investigation into local mosquito-borne transmission of Zika in Miami-Dade and Broward counties, including the measures that helped control Zika virus transmission in the Wynwood area.
As of September 28, 59 mosquito-borne cases of Zika have been reported in the United States. Zika continues to spread rapidly in other parts of the Americas, including Puerto Rico, where 21,535 locally acquired cases of Zika had been reported as of September 28. CDC continues to intensify activities to help Puerto Rico prevent Zika virus infection, especially among pregnant women. On September 30, CDC updated its interim guidance for preconception counseling and prevention of sexual transmission of Zika for people with possible Zika virus exposure. CDC also issued travel guidance for Zika virus in Southeast Asia.
World Rabies Day

On September 28, as CDC observed the 10th World Rabies Day, we were reminded that this deadly but preventable disease – one of the oldest diseases known to man – still keeps taking its toll, especially among the most vulnerable populations of the world. This global health observance was established in 2007 to raise awareness about the burden of rabies and to bring together partners to enhance prevention and control efforts worldwide. Around the globe, people are dying from this horrible disease due to lack of resources, animal control and vaccination programs, and education. CDC and other domestic and international health organizations are working diligently to help control and prevent rabies in the United States and the most affected countries. World Rabies Day is an opportunity to reflect on our efforts to control this deadly disease and remind ourselves that the fight is not yet over. Read about our work around the world and the burden of rabies here in the United States.
Partner Engagement for Patient Safety

CDC has been busy this month with numerous engagement opportunities with patient safety partners.
On September 29, CDC co-hosted a stakeholder meeting to kick off the Making Dialysis Safer for Patients Coalition. More than 60 attendees representing various dialysis-related organizations and hemodialysis providers have joined forces with CDC to implement CDC infection control recommendations and prevent bloodstream infections among patients undergoing hemodialysis.
In support of September’s Sepsis Awareness Month, CDC hosted a Twitter Chat with ABC News’ Dr. Richard Besser. The chat resulted in more than 54 million impressions. Other Sepsis awareness month activities included two webinars for clinicians and a leader in patient safety at CDC speaking at the Rory Staunton Foundation’s National Forum on Sepsis on September 12.
In September, the One & Only Campaign was on a fall conference tour to connect with healthcare providers and promote safe injection practices. The Campaign connected with more than 500 healthcare providers, distributed numerous resources and garnered invaluable feedback about injection safety in the field. The Campaign exhibited at the Pain Week’s 10th Annual Meeting, Nurse Anesthesia Annual Congress, and the International Health Facility Diversion Association 2016 Annual Conference.
Zika update

Throughout August, Zika has spread across many countries and territories, including the United States. The United States has 2,487 travel-associated cases as of August 24, 2016, and another area of active Zika transmission has been identified in a section of Miami Beach, in addition to the area of active Zika transmission near Wynwood in Miami-Dade County, Florida. CDC has issued guidance for people who live in or traveled to the identified area of Miami Beach any time after July 14. CDC has an Emergency Response Team in Florida to help, and Florida officials have responded quickly with mosquito control measures and a community-wide search for additional Zika cases. Zika continues to spread rapidly in other parts of the Americas, including Puerto Rico, where 8,746 locally acquired cases of Zika had been reported as of August 24. CDC continues to intensify activities to help Puerto Rico prevent Zika virus infection, especially among pregnant women.
As more is learned about Zika, CDC continues to update guidance and publish findings. The draft interim Zika response plan for the continental US and Hawaii has been revised to reflect new guidance and information. On August 2, CDC published an MMWR on “Contraceptive Use Among Nonpregnant and Postpartum Women at Risk for Unintended Pregnancy, and Female High School Students, in the Context of Zika Preparedness.” On August 19, CDC published an MMWR titled “Update: Interim Guidance for the Evaluation and Management of Infants with Possible Congenital Zika Virus Infection.” CDC is continuing its “Zika Topic of the Week” campaign, which highlights a simple prevention message each week.
Two foodborne Hepatitis A outbreaks

CDC has been assisting with two foodborne Hepatitis A outbreaks in Hawaii and Virginia.
The Hawaii Department of Health (HDOH), CDC, and FDA are investigating an outbreak of more than 200 cases of Hepatitis A on the islands of Oahu and Kauai. HDOH identified raw scallops served at Genki Sushi restaurants as a likely source of the ongoing outbreak. On August 18, Sea Port Products Corp. recalled three lots of frozen bay scallops after FDA testing identified Hepatitis A virus in samples of raw scallops collected from this company. The scallops were imported from the Philippines. A CDC Epi-Aid team was deployed on August 7 to Hawaii to assist with the investigation.
The Virginia Department of Health (VDH), CDC, and FDA are investigating another outbreak of Hepatitis A in Virginia. VDH has identified a link to smoothies prepared at Tropical Smoothie Café restaurants in Virginia, with a particular interest in imported frozen strawberries from Egypt used in the smoothies. Once notified of the outbreak, Tropical Smoothie Café withdrew the suspected strawberries from their restaurants in Virginia. CDC is working to identify any cases outside of Virginia linked to the outbreak, and FDA is conducting an investigation into the source of the strawberries and where else they may have been served.
CDC launches Antibiotic Resistance Lab Network including 7 new regional labs

As part of the $67 million provided to health departments in July to help tackle antibiotic resistance (AR) and patient safety threats nationwide, CDC announced the launch of the AR Laboratory Network—an effort to better detect and combat resistance threats through enhanced local lab capacity and stronger national coordination. The AR Lab Network consists of four CDC division labs, seven new regional labs (MD, MN, NY, TN, TX, WA, WI), and existing state and local health department labs in all 50 states and five major cities. Working together, these labs will conduct nationwide testing to fill data gaps and inform prevention and response for several urgent and serious pathogen threats including CRE, gonorrhea, Salmonella, Streptococcus pneumoniae, and Clostridium difficile. This ambitious approach transforms much of the current laboratory landscape and will increase local testing of hard-to-treat pathogens in order to detect resistance changes; improve detection, alerts, and response to new resistance mechanisms (like mcr-1); and establish the infrastructure needed to quickly ramp up special surveillance efforts when new threats emerge.
To date, the AR Lab Network team has hosted several technical calls with the new regional labs and will continue to scale up implementation throughout the fall. More about the funding announcement and the other efforts AR Solutions Initiative resources support can be found in this Washington Post Article.
Think Sepsis

CDC’s August Vital Signs focused on sepsis, emphasizing the importance of prevention and early recognition. Sepsis is a complication caused by the body’s overwhelming and life-threatening response to infection. It can lead to tissue damage, organ failure, and death. Sepsis is a medical emergency. Time matters.
September is Sepsis Awareness Month. Staff who worked on this issue of Vital Signs are using social media (#ThinkSepsis) to encourage people to share how sepsis has affected their family, friends, and loved ones. There will also be a CDC Twitter Chat with ABC News’ Dr. Richard Besser on September 13, at 1:00 pm EDT (#ABCDrBChat).
Zika update

In late July, CDC was informed by the State of Florida of the first known occurrence of local mosquito-borne Zika virus transmission in the United States. The Florida Department of Health identified an area in one neighborhood of Miami where Zika is being spread by mosquitoes. As a result, on August 1, CDC and Florida issued travel, testing and other recommendations for people who traveled to or lived in the Florida-designated areas on or after June 15, 2016, based on the earliest time symptoms can start and the maximum 2-week incubation period for Zika virus. At Florida’s request, CDC sent a CDC Emergency Response Team (CERT) with experts in Zika virus, pregnancy and birth defects, vector control, laboratory science, and risk communications to assist in the response. The draft interim Zika Response Plan for the continental US and Hawaii has been posted on the CDC website, and it will be updated as the situation evolves and we learn more.
Earlier in July, a CERT deployed to Utah to assist in the investigation of a case of Zika in a Utah resident who is a family member of the elderly Utah resident who died in late June and had been infected with the virus after traveling to an area with Zika. On July 18, CDC hosted a media briefing and posted a media statement on the Utah investigation.
Zika continues to spread rapidly in other parts of the Americas, including in Puerto Rico, where there were 5,460 locally acquired cases of Zika reported by August 3. CDC continues to intensify activities to help Puerto Rico prevent Zika virus infection, especially among pregnant women.
New studies, new insights
While we learn more about Zika, we continue to increase laboratory capacity for testing and update guidance as we get new information. We are also expanding our efforts to communicate Zika messages and report the information we have. In addition to publishing the number of Zika cases and the number of pregnant women with lab evidence of Zika, CDC has also begun reporting pregnancy outcomes for those with lab evidence of possible Zika virus infection. The information, which comes from the US Zika Pregnancy Registry and the Zika Active Pregnancy Surveillance System in Puerto Rico, includes pregnancy losses and live-born infants with birth defects in both the continental US and US territories.
CDC continues to share findings about Zika with the scientific community. On July 15, CDC published an early release of the MMWR Suspected Female-to-Male Sexual Transmission of Zika Virus—New York City, 2016. The publication identified the first case of female-to-male sexual transmission of Zika virus. On July 25, CDC updated its interim guidance for health care providers in the United States caring for pregnant women with possible Zika virus exposure, and its interim guidance for the prevention of sexual transmission of Zika virus.
An article by CDC’s Infectious Disease Pathology Branch and published recently in The Lancet, reported on the severity of Zika infection, especially during a woman’s first trimester of pregnancy, and a range of birth defects including microcephaly, and head, facial, spine and joint malformations. The Pathology Branch staff studied five cases from Brazil including two newborns with birth defects who died shortly after birth, a third baby who died at 2 months, as well as two spontaneous abortions linked to Zika.
CDC gives $240M to states

In late July, CDC announced an award of $240 million to help states detect, prevent, and respond to the growing threats posed by emerging and re-emerging infectious diseases, such as Zika virus and antibiotic resistance. The funding is being distributed through CDC’s Epidemiology and Laboratory Capacity for Infectious Diseases (ELC) Cooperative Agreement, which oversees an array of cross-cutting epidemiology, laboratory, and health information systems activities that help domestic public health departments respond to complex infectious disease threats.
Since ELC’s inception, this funding mechanism has grown from assisting eight grantees with $2 million dollars to providing $90-240 million annually (2011 – 2016) to all 50 states, 8 U.S. territories, and 6 cities with the largest local health departments. In fact, the award distributed in August is the largest amount dispersed since the ELC Cooperative Agreement started.
Don’t eat the cookie dough!

At least 46 people in 21 states have been infected with strains of Escherichia coli (E. coli) O121 or E. coli O26 and the investigation has linked their illnesses to exposure to flour produced by General Mills in Kansas City, Missouri. Ill people reported eating raw dough or raw batter before getting sick. Several children reported playing with raw dough at restaurants. As a result of the investigation, many different flours and products containing flour have been recalled by General Mills and their customers. CDC’s investigation is ongoing. Eating raw dough or batter is a known risky practice and has been linked to illnesses and outbreaks in the past. This investigation is the first multistate outbreak of E. coli infections definitively linked to flour: epidemiologic, microbiologic, and traceback evidence all points to General Mills’ flour as the source of the outbreak.
Yuck: Harmful algal blooms

Harmful algal blooms are the rapid growth of algae that can cause harm to animals, people, or the local ecology. Algal blooms can look like foam, scum, or mats on the surface of water and can be different colors. They can produce toxins that have caused a variety of illnesses in people and animals. Harmful algal blooms can occur in warm fresh, marine, or brackish waters with abundant nutrients and are becoming more frequent with climate change.
CDC recently launched One Health Harmful Algal Bloom System (OHHABS), a voluntary reporting system available to state and territorial public health departments and their designated environmental health or animal health partners. OHHABS collects data on individual human and animal cases of illnesses from harmful algal bloom-associated exposures, as well as environmental data about the blooms. This information will support the understanding and prevention of harmful algal blooms and associated illnesses. The team concurrently launched a new website for harmful algal blooms, issued a media advisory announcing the launch of OHHABS and the new website, and shared information on social media.
Zika Update
The month of May saw an uptick in Zika activities – notably in CDC’s efforts to prepare for the Olympics in Brazil, and in preparing for the possibility of a first locally acquired case of Zika in the continental United States. CDC, along with state and local health departments across the country, is ramping up preparedness activities as the weather gets warmer. Meanwhile, the outbreak continues to spread across the Americas, with several new travel notices posted during the past month.
We learn more about Zika every day, and one of our primary activities is increasing laboratory capacity for testing and updating our guidance as we get new information. For example, recent data indicate that Zika virus RNA is unlikely to be detected in serum after the first week of illness, but that it can be detected in urine for at least 2 weeks after symptoms first appear. Based on this new information, we have released new interim guidance and a Health Alert Network (HAN) health update about testing urine in patients with suspected Zika virus disease, and we have also revised guidelines for submitting body fluids for testing.
On May 20, we also announced some adjustments in how we report Zika virus infection in pregnant women to cover a broader population of pregnant women at risk for Zika. We are now using numbers from the US Zika Pregnancy Registry and the Zika Active Surveillance System in Puerto Rico and will report pregnant women with any lab evidence of possible Zika virus infection, with or without symptoms. These numbers can be found on the Zika website.
Zika specimen repository

Early during the Zika outbreak, an interagency working group was established to assist in the development of a Zika specimen repository. CDC’s Division of Scientific Resources was selected as the central location for management and storage of this critical collection.The repository team is managing a collection of over 250 clinical samples from the US, Puerto Rico, and Panama with shipments expected from other countries in the future.
This repository is intended to support the generation of validation panels for the state and local public health laboratories as they begin conducting tests to detect the virus. To date, more than 100 Zika specimen shipments have gone out to Laboratory Response Network US labs as well as to US Department of Defense laboratories worldwide. Additionally, the repository supported the creation of five panels that were distributed to five commercial entities with promising assays in development. This project was established in partnership with the Biomedical Advanced Research and Development Authority and is critical to ensuring that high-quality commercial assays are available in the future. The hard-working repository staff and shipping team have established an operation that can be a successful model for future global outbreaks.
Healthy and Safe Swimming Week makes a splash

May 23 marked the start of the 12th annual Healthy and Safe Swimming Week. To help pique public interest in advance of the Week, CDC’s Waterborne Disease Prevention Branch (WDPB) released an MMWR surveillance summary on pool and hot tub/spa inspection data, which found that every year, serious health and safety violations force thousands of public pools, hot tubs, and water playgrounds to close. The report attracted media attention from CNN, ABC News, CBS News, and Reuters. WDPB kicked off the week with a Twitter Chat cohosted with @NBCNewsHealth and launched their new Healthy Swimming website.
Inappropriate use of antibiotics in doctor’s office and emergency rooms
On May 3, CDC’s Division of Healthcare Quality Promotion in collaboration with Pew Charitable Trusts, released findings in the Journal of the American Medical Association on the inappropriate use of antibiotics in doctor’s offices and emergency departments. At least 30% of antibiotics prescribed in the United States are unnecessary, which is about 47 million excess prescriptions that put people at unnecessary risk for allergic reactions or infection with the sometimes deadly diarrhea-causing bacteria Clostridium difficile. CDC promotions included an op-ed authored by Dr. Frieden, and the findings were featured in more than 160 news stories, including 10 international outlets.
Solve the “Mystery at the Border” with CDC app

CDC’s Division of Global Migration and Quarantine’s US-Mexico Unit, in collaboration with subject matter experts from the Environmental Health Services Branch and CDC’s Division of High-Consequence Pathogens and Pathology, recently released the “Mystery at the Border” outbreak scenario in the second level of CDC’s Solve the Outbreak app. This fictitious scenario is based on a Guillain-Barré syndrome (GBS) binational outbreak in which the US-Mexico unit participated in 2011. Players are presented with different layers of information and data—case distribution maps, an odds ratio table from a case control study, and bacteria tests results—to determine the cause of the mysterious cases of paralysis in a small Arizona border town. This scenario is particularly relevant as the threat of GBS as a potential complication of Zika infection may be present along our southern land border.
Zika Update
In April we saw no sign of the Zika outbreak slowing down, but we continue to break new ground in understanding this virus, allowing us to strengthen and hone our efforts to protect those most at risk. At the same time, we are continuing to prepare for the very real possibility that we will see cases of locally acquired Zika in the United States.
Cases of Zika continue to increase – as of April 27, there were 426 travel-associated cases reported in US states, and 600 locally acquired cases in Puerto Rico, the US Virgin Islands, and American Samoa. New travel notices were posted for Belize, Saint Lucia, Fiji, and Kosrae (Micronesia), bringing the total number of affected countries and territories to 43.
Work on the response continued at a feverish pace at CDC in April. Along with the successful ZAP Summit held April 1, which provided state and local senior officials with information and tools needed to improve Zika preparedness and response, CDC released the April issue of Vital Signs, which focused on Zika and pregnancy, highlighting the potential consequences of Zika infection for pregnant women. Although there are still many unanswered questions about Zika, the issue identified many actions that can be taken—by federal, state, and local agencies; healthcare providers; and individuals—to protect pregnant women.
Research and laboratory activities
In an article published this month in the New England Journal of Medicine, CDC scientists made a significant contribution to Zika research. After a rigorous review of existing evidence, the authors concluded that Zika virus is a cause of microcephaly and other severe fetal brain defects. Establishing this causal relationship will help us to improve and focus our research and response efforts so that we can better understand Zika and how it affects pregnancies.
DVBD labs in Fort Collins have eliminated the backlog of specimens awaiting molecular and serological testing as more state labs have come online. But as the annual summer transmission for vector-borne diseases begins in North America, we must all be prepared to deal with not only Zika, but also West Nile, St. Louis, chikungunya, and other arboviruses, as well as Lyme, plague, tularemia, and Rocky Mountain spotted fever. The Puerto Rico Department of Health and the Dengue Branch continue their relentless pursuit of defeating Zika—developing innovative diagnostics, finding effective ways of eliminating Aedes aegypti mosquitoes, and communicating with the public about prevention.
Sharing Zika research

CDC neuroepidemiologist Jim Sejvar recently presented his team’s study on Guillain Barré syndrome (GBS) and its association with Zika virus at the American Academy of Neurology’s annual conference, which drew 11,000 participants and is the world’s largest gathering of neurologists. Jim presented preliminary findings from the case-control study that CDC and Brazilian colleagues began in January.
Among the insights he shared:
- Cases of GBS in Brazil are nearly 5 times the number we’d expect.
- About half of GBS patients were still experiencing moderate to severe symptoms 6 months after they became ill.
- Nearly 90% of GBS patients reported a Zika-like illness before their GBS symptoms.
Immediately following the meeting, Jim jetted off to Colombia to join the team that’s launching a similar case-control study on GBS and Zika there. Clips from the conference are here and here.
Zika in the media
Time Magazine reporter Alexandra Sifferlin visited CDC in Atlanta on April 20 to interview CDC experts about the Zika response. She also visited the Dengue Branch in Puerto Rico on April 22 and spoke with experts working on the response. A story titled, “Why America’s Top Health Official Is Worried About Zika” ran in April and the cover story is tentatively scheduled for the week of May 2.
New cases of yellow fever in Africa and in Peru
The yellow fever epidemic continues in Angola where, as of April 26, more than 2,000 suspected cases (> 650 confirmed) have been reported, including 257 deaths. The immunization program is accelerating but will draw down the world vaccine reserves to a low level that could impede response to additional epidemics before the supply can be replenished in 3 to 6 months. CDC staff have been deployed to Luanda for 5 weeks to help conduct serological and molecular testing and to evaluate CDC’s new IgM MAC-ELISA, which yields results in 4 hours instead of 2 days.
In the meantime, a cluster of confirmed yellow fever cases has been detected in Masaka, Uganda. This outbreak, which does not appear to be connected to the Angola epidemic, is in the southeastern part of the country, not typically endemic for yellow fever. The index case patient was a charcoal maker who might have been infected when cutting trees in the forest. As of late April, there are 30 confirmed, probable, and suspected cases, including 6 deaths.
In addition to the outbreaks in Africa, the Pan American Health Organization reported that through the first week of April, there were 25 suspected and 9 confirmed cases of yellow fever, including 2 deaths in central Peru. The number of cases reported in 2016 exceeds the total of cases reported in the preceding 2 years. Currently, Peru is the only country in the Americas to report confirmed yellow fever in 2016.
Newly identified cluster of Elizabethkingia
CDC continues to work with states to investigate the multistate outbreak of Elizabethkingia anophelis that has sickened 61 people and caused 20 deaths in Wisconsin, Illinois, and Michigan to date. On April 20, Illinois health officials announced a newly identified cluster of an additional 10 cases and 6 deaths in Illinois residents since January 1, 2014. Recent testing of the specimens by CDC’s Special Bacteriology Reference Laboratory confirmed that the same strain made the 10 people sick, but it showed that the strain is distinct from the strain that has been identified in Wisconsin. Investigation into the Wisconsin outbreak has led to increased awareness of Elizabethkingia and additional reporting of cases to CDC. Advanced Molecular Detection-related technological advancements in laboratory testing have allowed scientists to differentiate E. anophelis from other types of Elizabethkingia and to identify patient clusters within this species. As CDC and state health departments work together to investigate these outbreaks, other clusters may be identified. Meanwhile, experts continue to work to identify possible sources of exposure in the outbreak.
Rocky Mountain spotted fever prevention

In March, Epidemic Intelligence Service Officers from CDC (EISO) provided technical assistance to the University of Sonora and Sonoran Secretary of Health as they kicked off a pilot project to prevent Rocky Mountain spotted fever in a high-incidence section of Hermosillo, Mexico. In this first visit, more than 530 homes were registered to participate in the project and received environmental pesticide applications. Roughly 800 dogs were treated with acaricidal products such as tick collars, and almost 550 knowledge, attitudes, and practices surveys were administered in the intervention and control communities. Teams will return to help with monitoring every other month starting in May.
Zika Update

Zika continues to spread to new areas in South and Central America, the Caribbean, and the Pacific Islands, and NCEZID remains an active player in the global response to the outbreak. CDC added five countries to its travel notice for Zika in March: Cuba, Dominica, New Caledonia, Saint Vincent and the Grenadines, and Sint Maarten. We are especially concerned about Puerto Rico, where the highest number of locally transmitted Zika virus disease cases in the US territories has been reported. The number of cases will likely rise with increasing mosquito activity, resulting in increased risk for transmission to pregnant women. We are working in partnership with the Puerto Rico Department of Health to protect pregnant women using multiple approaches including the distribution of Zika Prevention Kits and focusing vector control efforts on their homes. One way to reduce adverse pregnancy and birth outcomes is to facilitate access to an effective contraceptive method for the estimated 138,000 women of reproductive age in Puerto Rico who do not desire pregnancy but are not using a contraceptive. Access to contraception is constrained by limited availability, high cost, and other factors. As a recent MMWR on this topic suggested, removing barriers to contraception can lead to reduced rates of unintended pregnancy, which would result in fewer adverse pregnancy and birth outcomes associated with Zika in Puerto Rico. CDC and other partners have initiated multiple approaches to address some of these barriers.
Local transmission of Zika has still not been reported in the continental United States, but as of March 30, there were 312 travel-associated cases reported in 41 states and Washington, DC. Of those 312 cases, 27 were in pregnant women, 6 were sexually transmitted, and 1 had Guillain-Barré syndrome. As the weather warms up, it’s likely we will see cases transmitted via mosquitoes here in the continental United States. We’ve been working hard to make sure states are prepared for that possibility. One way we’re doing this is through the Zika Action Plan (ZAP) Summit, which was held at CDC on April 1.
Providing resources and guidance
CDC also continues to provide tools and resources for travelers, pregnant women, healthcare providers, and others. The US Zika Pregnancy Registry is now available online and will help us collect information about Zika infection during pregnancy. The data collected will be used to update recommendations and help improve prevention and care services for pregnant women and families affected by Zika. Throughout March, a number of publications have been posted on the Zika website on a variety of topics including guidance about preventing sexual transmission in the United States and providing health care for women with possible Zika exposure, as well as a communication planning guide for states, to name just a few.
Activity in the labs
The past month has also seen amazing output from NCEZID laboratories, with two new diagnostic tests issued Emergency Use Authorizations (EUAs) by the FDA. These tests will expand capacity for US labs to test for Zika and help us to rapidly detect cases. An EUA was issued for a CDC-developed test (Zika MAC-ELISA) that detects antibodies that the body makes to fight a Zika virus infection. Currently, 15 US state public health laboratories (2 labs in Florida) are qualified to use this test.
The Trioplex RT-PCR Assay, developed by CDC’s Dengue Branch, was authorized on March 17. The Trioplex combines three tests (for Zika, dengue, and chikungunya) into one, reducing costs and increasing throughput. The Trioplex has been adapted to be run on equipment that is common in public health labs in the United States and abroad.
CDC’s Division of Vector-Borne Diseases is receiving more than 1,000 Zika specimens a week. Starting March 21, the Bacterial Diseases Branch expanded testing capacity in their laboratories to expand over all capacity in Fort Collins, Colorado. The laboratory at the Dengue Branch in Puerto Rico, currently is receiving about 200 samples per day. Although the testing volume in Fort Collins likely will diminish as states develop capacity, CDC labs will continue to play a pivotal role in diagnostic testing for the foreseeable future.
Dengue Branch continues to play a huge role in our response, supporting the Puerto Rico Department of Health in all aspects of the response, conducting mosquito testing to get a sense of insecticide resistance of Aedes aegypti and scaling up testing capacity to accurately diagnose and protect pregnant women on the island.
April 1 ZAP Summit

Hosted by CDC, the Zika Action Plan Summit on April 1 brought together officials from local, state, and federal jurisdictions, as well as non-governmental organizations to prepare for a coordinated US response to Zika. The United States likely faces local mosquito-borne transmission of Zika virus in some places in the continental United States; local transmission means the mosquitoes in an area are infected with the virus and have spread it to humans. The Commonwealth of Puerto Rico, US Virgin Islands, and American Samoa already are experiencing local mosquito-borne transmission of Zika. The US government planned this Summit to give state and local senior officials the information and tools they need to improve their ability to prepare for and respond to local Zika transmission in their states and jurisdictions. The goal is to arm state and local leaders with the knowledge and technical support they need to have a comprehensive Zika Readiness Action Plan for their jurisdictions.
Massive yellow fever outbreak poses global threat

On March 30, the Angola Ministry of Health reported that the yellow fever outbreak has resulted in more than 1,400 suspected cases, 490 confirmed cases, and 198 deaths. The outbreak threatens to spill into neighboring countries. More than 5 million doses of vaccine have been distributed, and the Angola Ministry of Health (MoH) is using an additional 1 million vaccine doses to complete vaccination campaigns in the remaining municipalities of Luanda where vaccine is needed. However, the MoH and WHO are currently requesting about 3.5 million more yellow fever vaccine doses to cover outlying provinces. Cases have been reported among travelers returning home to China, Kenya, the Democratic Republic of Congo, and Mauritania. Aedes aegypti mosquitoes that transmit dengue and Zika viruses also transmit yellow fever virus. CDC is concerned about the spread of yellow fever to other African countries because of a shortage of vaccine.
CDC has issued a Travel Health Notice (level 1, watch – “practice usual precautions”) for people traveling to Angola. Travelers to countries with endemic yellow fever should be vaccinated.
CDC’s has been providing critical support to the response, with consultation with WHO and others on the response strategy. CDC’s vector-borne experts also manufactured 140 ready-to-use IgM test kits that includes premade, premeasured components that can be stored for at least 6 months without the need for freezing and are capable of testing approximately 3,360 specimens. Other CDC staffers were deployed to Luanda to help with testing. They also trained laboratorians on how to use the test kits and how to run the reverse transcription polymerase chain reaction (RT-PCR) test for yellow fever.
Searching for the culprit in a deadly outbreak

CDC’s laboratory scientists and epidemiologists have been hard at work trying to find the culprit in the ongoing Elizabethkingia anophelis outbreak that has so far sickened more than 56 people in Wisconsin and 1 in Michigan, leading to 18 deaths. Epi investigations and hundreds of tests haven’t yet been able to identify a common exposure among patients or a common environmental link. We have, however, learned a significant amount about this organism, including that it can survive in alcohol and high temperatures. Because we have also used new technologies like MALDI-ToF and whole genome sequencing, we have discovered that this species, E. anophelis, once thought to be rare, is more common than we previously thought.
March Vital Signs: US doing a better job preventing HAIs

According to the March Vital Signs, America is doing a better job of preventing healthcare-associated infections (HAIs), but more work is needed – especially in fighting antibiotic-resistant bacteria. The report urges healthcare workers to use a combination of infection control recommendations to better protect patients from these infections.
The MMWR shows that many of the most urgent and serious antibiotic-resistant bacteria threaten patients while they are being treated in healthcare facilities for other conditions, and may lead to sepsis or death. In acute care hospitals, 1 in 7 catheter- and surgery-related HAIs can be caused by any of the 6 antibiotic-resistant bacteria. That number increases to 1 in 4 infections in long-term acute care hospitals, which treat patients who are generally very sick and stay, on average, more than 25 days.
Along with this report, CDC released two other resources:
- The updated annual progress report on HAI prevention shows acute care hospitals achieved a 50% decrease in central line-associated bloodstream infections (CLABSIs) between 2008 and 2014, but 1 in 6 remaining CLABSIs are caused by urgent or serious antibiotic-resistant bacteria. The report also shows that progress was made in decreasing hospital-onset C. difficile infections by 8% between 2011 and 2014.
- The Antibiotic Resistance Patient Safety Atlas is a new web app with interactive data on HAIs caused by antibiotic-resistant bacteria. This tool provides national, regional, and state map views of superbug/drug combinations showing the percentage of these superbugs that are resistant to antibiotics over time. The atlas uses data that more than 4,000 healthcare facilities reported to CDC’s National Healthcare Safety Network from 2011 to 2014.
Zika Update
Zika dominated the headlines in February, its reach extending to all corners of CDC as we escalated our efforts to contain the outbreak and learn more about this complex and multidimensional disease. The National Center for Emerging and Zoonotic Infectious Diseases (NCEZID) is leading CDC’s response, working in close collaboration with other CDC centers as well as US and global partners.
CDC’s response to Zika is expanding as the virus continues to spread across the Americas and Pacific islands. On February 1, the World Health Organization declared Zika a Public Health Emergency of International Concern because of clusters of microcephaly and other neurological disorders in some of the affected areas. On February 8, CDC elevated its response efforts to a Level 1 activation, the highest response level at the agency, previously used only for H1N1, Hurricane Katrina, and Ebola.
CDC’s travel notices for Zika now cover more than 30 countries and US territories. Thus far, Zika has not been spread by mosquitoes in the continental United States, although cases have been reported in travelers returning to the United States. Cases of sexual transmission have also been reported and are being investigated. The agency continues to release guidelines for healthcare providers, laboratories, and other groups as we learn more about this disease—most importantly its link to birth defects. In addition to our work here at headquarters, CDC staff have been deployed to Brazil, Panama, and the US territories of Puerto Rico, American Samoa, and the US Virgin Islands.
Leading the charge
NCEZID’s Division of Vector-Borne Diseases (DVBD) has taken a leadership role in the response and is engaged on numerous fronts. In addition to contributing subject matter expertise, DVBD staff are leading several epidemiological investigations, including a case-control study in Brazil to further investigate the link between Zika virus and microcephaly. DVBD laboratorians are playing a critical role, even beyond testing more than 1,000 clinical specimens of Zika that have been submitted by state health departments. The division’s labs have also developed all the data for emergency use authorization (EUA) submission of assays and distributed reagents for the assays.
Other NCEZID divisions are supporting the response in a variety of ways. The Division of High-Consequence Pathogens and Pathology’s Infectious Diseases Pathology Branch (IDPB) Lab played a key role in making the link between Zika infection and miscarriage or microcephaly. IDPB staff developed tests to detect Zika virus in tissue samples. They performed the tests on tissue samples from two babies with microcephaly who died shortly after birth and tissues from two miscarriages. All four mothers reported having Zika symptoms during their first trimester. They found Zika virus in all of the samples, and it was the same strain of Zika that has been circulating in Brazil. These findings are the strongest evidence yet of a link between Zika and microcephaly or fetal loss. Another group from DHCPP recently traveled to Brazil to study the potential association between Zika virus infection and Guillain-Barré syndrome.
Also, the Division of Global Migration and Quarantine has regularly updated travel notices to reflect the expansion of the outbreak; the Division of Healthcare Quality Promotion has been working with FDA to ensure the safety of the blood supply in Puerto Rico as well as in the US and US territories; the Division of Preparedness and Emerging Infections has assisted with EUA submission for Zika tests; and the Division of Scientific Resources has manufactured PCR diagnostic kits to test for active infection of Zika virus.
Antibiotic Resistance Solutions Initiative

With $160 million in marked funding from Congress, CDC’s Antibiotic Resistance (AR) Solutions Initiative will be able to transform how CDC and public health partners tackle and slow antibiotic resistance at all levels. It will empower the nation to respond comprehensively, efficiently, and effectively to one of the world’s biggest infectious disease threats and will result in collaborations involving many centers at CDC working with a number of private and public partners, including state health departments. The AR Solutions Initiative will support several critical programs and projects as well as new and ongoing CDC work, including:
- The AR Regional Lab Network, for nationwide detection of new and known threats, and expanded capacity for 50 state labs to track and stop CRE (carbapenem-resistant Enterobacteriaceae).
- State prevention programs to drive adoption of a coordinated approach to improve infection control.
- Robust systems to track resistance, antibiotic use, and infections in the community and healthcare settings.
- Education and prevention for antibiotic stewardship and sepsis recognition and prevention.
- Expanded overseas TB screenings and a national TB stockpile to prevent shortages of medicine needed to treat TB.
- Increased capacity for state laboratories to rapidly investigate outbreaks of antibiotic-resistant foodborne infections using whole genome sequencing.
- Rapid detection, tracking, and treatment for antibiotic-resistant gonorrhea.
The risk of sprouting

Three foodborne outbreaks linked to sprouts and sprouted products are currently under investigation by CDC’s Outbreak Response Team:
- Multistate outbreak of 18 Salmonella Virchow infections in 15 states linked to Garden of Life RAW Meal powdered meal replacement products.
- Multistate outbreak of 13 Salmonella Muenchen infections in 4 states linked to alfalfa sprouts produced by Sweetwater Farms of Inman, Kansas.
- Multistate outbreak of 9 E. coli O157:H7 infections in 2 states linked to alfalfa sprouts produced by Jack & The Green Sprouts of River Falls, Wisconsin.
Sprouts are a known source of foodborne illness. Children, older adults, pregnant women, and people with weakened immune systems should avoid eating raw sprouts of any kind (including alfalfa, clover, radish, and mung bean sprouts). The current outbreak linked to Garden of Life RAW Meal powdered meal replacement is the third multistate outbreak in recent years linked to a sprouted product (rather than the sprouts themselves); the other contaminated products were raw, sprouted nut butters and chia powder.
2015 NCEZID Accomplishments now online!

The annual recap of highlights of NCEZID work and accomplishments is now online. NCEZID works to protect people at home and around the world from emerging and zoonotic diseases from A to Z—anthrax to Zika. These highlights include responses to several domestic and global outbreaks, getting Ebola on the road to zero, the ramped-up plans to reduce antibiotic resistance, and some remarkable examples of discovery and innovation that took place in 2015. We include a “looking ahead” page, written just as Zika was appearing on the horizon. The infectious disease timeline is a good reminder of the tremendous work to prevent infections and save lives that NCEZID has accomplished in the first half of the decade.
Zika virus continues to spread

In May 2015, the Pan American Health Organization issued an alert regarding the first confirmed Zika virus infection in Brazil. Zika is a mosquito-borne virus that causes an illness with usually mild symptoms lasting from several days to a week in only about 20% of infected people; most people have no symptoms.
However, during the current outbreak, there have been reports of a serious birth defect of the brain called microcephaly and other poor pregnancy outcomes in babies of mothers who were infected with Zika virus while pregnant. Knowledge of the link between Zika and these outcomes is evolving, but until more is known, CDC is recommending special precautions for pregnant women and women trying to become pregnant. Beginning January 15, CDC began issuing travel alerts (Level 2-Practice Enhanced Precautions) for people traveling to countries where Zika virus transmission is ongoing. The notices recommend that pregnant women consider postponing travel to any of these areas. For women trying to become pregnant, CDC recommends that they talk to their doctor before travel about the risk of Zika virus infection. More studies are planned to better understand the risks of Zika virus infection during pregnancy. Additionally, a team from CDC is currently in Brazil to investigate another issue—an outbreak of Guillain-Barré syndrome (GBS) that coincides with Zika’s arrival. There is much to be done to better understand and control this emerging infectious disease.
Outbreak of listeriosis linked to packaged salads

Since September 2015, CDC has been collaborating with public health officials in several states and the US Food and Drug Administration (FDA) to investigate a multistate outbreak of Listeria monocytogenes infections (listeriosis) linked to packaged salads. As of January 28, a total of 15 people from 8 states were reported to have been infected. All 15 people were hospitalized, including 1 person from Michigan who died. Packaged salads produced at the Dole processing facility in Springfield, Ohio, and sold under various brand names are the likely source of this outbreak. The Ohio Department of Agriculture isolated Listeria from Field Greens packaged salad produced at Dole’s Springfield processing facility, and whole genome sequencing showed that the isolate from the salad was highly related genetically to isolates from the ill people. On January 21, Dole stopped all production at the Springfield processing facility and withdrew all packaged salads currently on the market that were produced at this facility. CDC and state and local public health partners are continuing laboratory surveillance through PulseNet to identify additional ill people and to interview them.
New investment in combating antibiotic resistance

In December, Congress passed the spending bill that included $160 million for the Antibiotic Resistance (AR) Solutions Initiative. The AR Solutions Initiative provides critical increased investment in CDC programs to combat antibiotic-resistant bacteria. The funding will support better tracking of antibiotic use and resistance, improved prescribing practices, state protect programs, and an AR regional lab network. More specifics on the roll-out of the plan will come in the next few months.
Emergence of antifungal resistance in a common fungus

The fungus Candida is now the most common cause of hospital-associated bloodstream infections in the United States. Some species, like Candida glabrata, are showing increased resistance to multiple classes of antifungal medications, such as azoles and echinocandins. As a result, patients with these resistant infections have few remaining treatment options. CDC’s Mycotic Diseases Branch has published a reportdescribing the epidemiology and risk factors for echinocandin-resistant C. glabrata bloodstream infections. The proportion of C. glabrata infections that were resistant to echinocandins nearly doubled from 2008 through 2014. At some hospitals, nearly a quarter of these infections were resistant to echinocandins. Prior echinocandin exposure was significantly associated with resistant C. glabrata infection; however, more than half of the patients infected with echinocandin-resistant C. glabrata had no known prior exposure to the antifungal medication, suggesting possible transmission of echinocandin-resistant C. glabrata between patients.
- Page last reviewed: February 3, 2017
- Page last updated: February 3, 2017
- Content source:
Centers for Disease Control and Prevention
National Center for Emerging and Zoonotic Infectious Diseases (NCEZID)
ShareCompartir